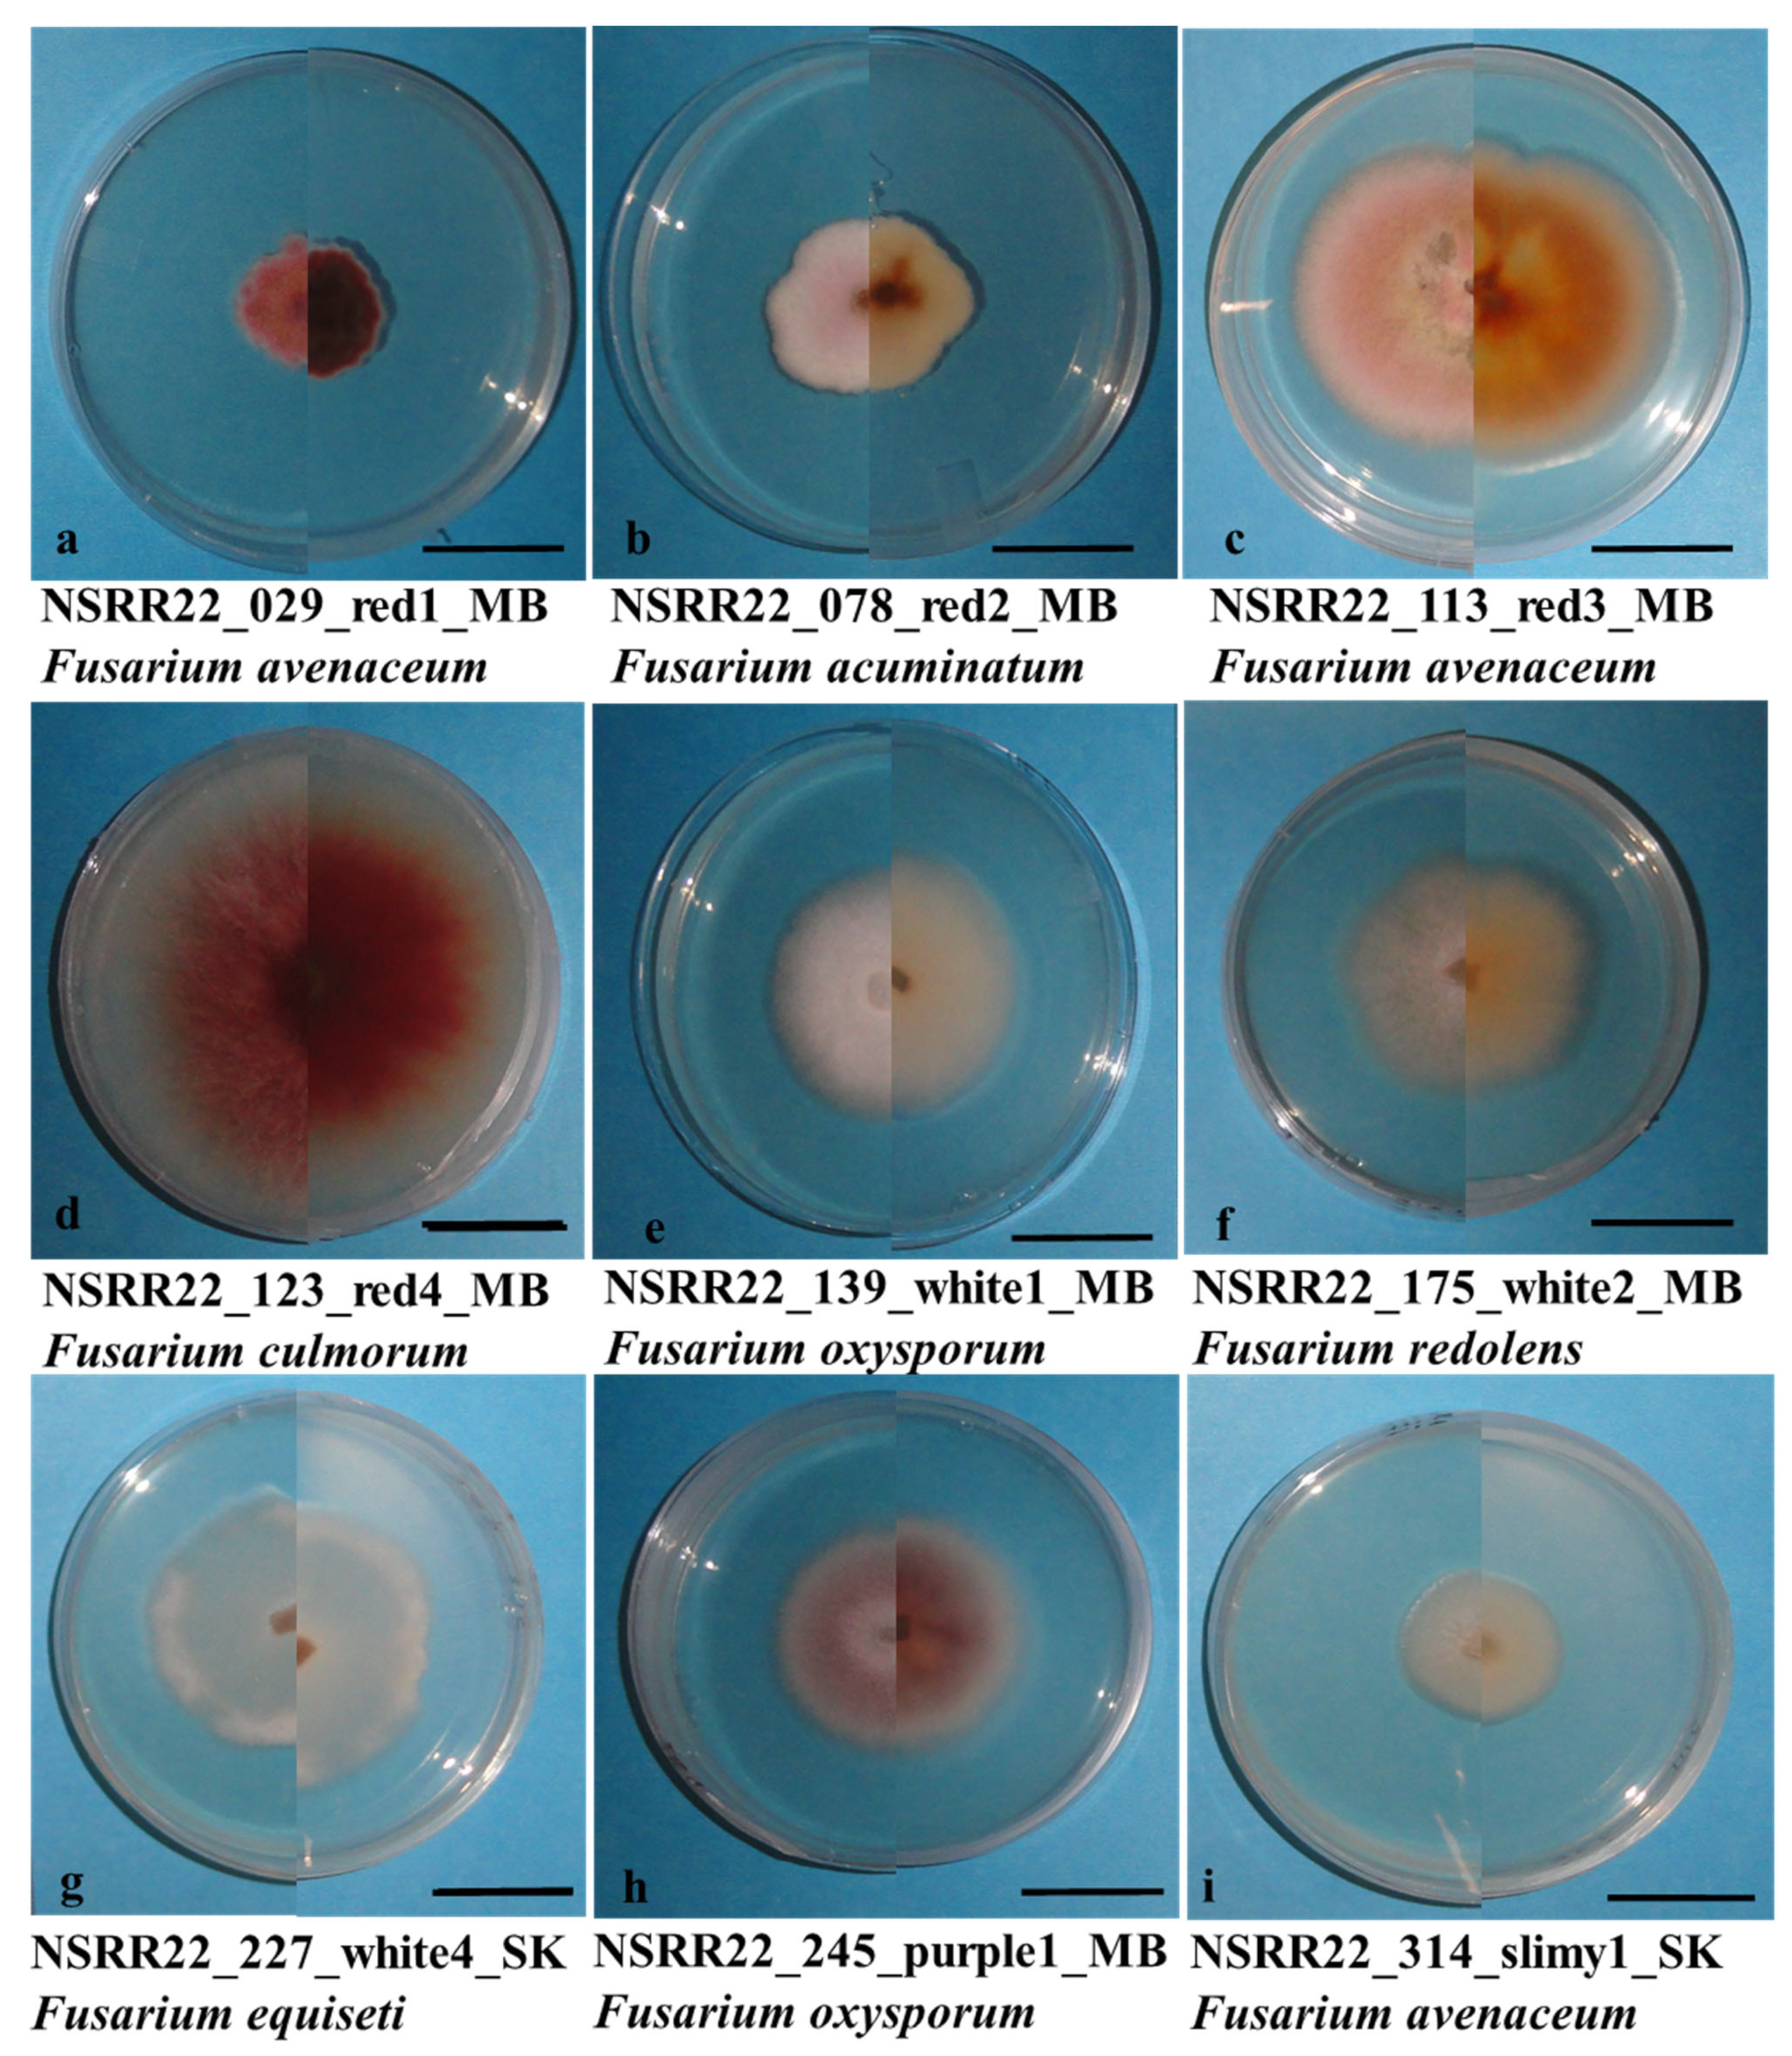
Jof 10 00303 g004

Pathogenicity, Host Resistance, and Genetic Diversity of Fusarium Species under Controlled Conditions from Soybean in Canada
Abstract
1. Introduction
2. Materials and Methods
2.1. Fungal Material and Inoculum Preparation
2.2. Pathogenicity Test
2.3. Evaluation of Resistance
2.4. Greenhouse Data Collection
2.5. Fungal Isolation from Field Samples
2.6. DNA Extraction, PCR Amplification, and Sanger Sequencing
2.7. Phylogenetic Analysis
2.8. Data Analysis
3. Results
3.1. Pathogenicity Test
3.2. Cultivar Resistance Evaluation
3.3. Fusarium spp. Identification
3.4. Phylogenetic Analysis
4. Discussion
5. Conclusions
Supplementary Materials
Author Contributions
Funding
Institutional Review Board Statement
Informed Consent Statement
Data Availability Statement
Acknowledgments
Conflicts of Interest
References
- Michelfelder, A.J. Soy: A Complete Source of Protein. Am. Fam. Physician 2009, 79, 43–47. [Google Scholar]
- Voora, V.; Larrea, C.; Bermúdez, S. Global Market Report: Soybeans. 2020. Available online: https://www.jstor.org/stable/resrep26554 (accessed on 4 July 2023).
- Shahbandeh, M. Production of Soybeans in Leading Countries Worldwide. 2012–2023. Available online: https://www.statista.com/statistics/263926/soybean-production-in-selected-countries-since-1980/ (accessed on 25 April 2023).
- Government of Canada; Statistics Canada. Estimated Areas, Yield, Production, Average Farm Price and Total Farm Value of Principal Field Crops, in Metric and Imperial Units. Available online: https://www150.statcan.gc.ca/t1/tbl1/en/tv.action?pid=3210035901 (accessed on 17 April 2023).
- Barthet, V.J.; Puvirajah, A. Quality of Canadian Oilseed-Type Soybeans 2022. 2022. Available online: https://grainscanada.gc.ca/en/grain-research/export-quality/oilseeds/soybean-oil/2022/pdf/quality-report-soybean-oilseed-type-2022.pdf (accessed on 4 July 2023).
- Agriculture and Agri-Food Canada. Canada: Outlook for Principal Field Crops, 2022-11-18. Available online: https://publications.gc.ca/collections/collection_2022/aac-aafc/A77-1-2022-11-18-eng.pdf (accessed on 25 April 2023).
- Hartman, G.L.; Sinclair, J.B.; Rupe, J.C. Compendium of Soybean Diseases, 4th ed.; APS Press, The American Phytopathological Society: St. Paul, MN, USA, 1999; ISBN 0-89054-238-4. [Google Scholar]
- Bradley, C.A.; Allen, T.W.; Sisson, A.J.; Bergstrom, G.C.; Bissonnette, K.M.; Bond, J.; Byamukama, E.; Chilvers, M.I.; Collins, A.A.; Damicone, J.P.; et al. Soybean Yield Loss Estimates Due to Diseases in the United States and Ontario, Canada, from 2015 to 2019. Plant Health Prog. 2021, 22, 483–495. [Google Scholar] [CrossRef]
- Hafez, M.; Abdelmagid, A.; Aboukhaddour, R.; Adam, L.R.; Daayf, F. Fusarium Root Rot Complex in Soybean: Molecular Characterization, Trichothecene Formation, and Cross-Pathogenicity. Phytopathology 2021, 111, 2287–2302. [Google Scholar] [CrossRef]
- Díaz Arias, M.M.; Munkvold, G.P.; Ellis, M.L.; Leandro, L.F.S. Distribution and Frequency of Fusarium Species Associated with Soybean Roots in Iowa. Plant Dis. 2013, 97, 1557–1562. [Google Scholar] [CrossRef]
- Díaz Arias, M.M.; Leandro, L.; Munkvold, G. Frequency of Isolation, Aggressiveness, and Impact on Yield of Fusarium Root Rot Species in Soybean in Iowa. Phytopathology 2012, 102, S4.30. [Google Scholar]
- Michielse, C.B.; Rep, M. Pathogen Profile Update: Fusarium oxysporum. Mol. Plant Pathol. 2009, 10, 311–324. [Google Scholar] [CrossRef]
- Armstrong, G.M.; Armstrong, J.K. Biological races of the Fusarium causing wilt of Cowpea and Soybeans. Phytopathology 1950, 40, 181–193. [Google Scholar]
- Zhou, Q.; Li, N.; Chang, K.-F.; Hwang, S.-F.; Strelkov, S.E.; Conner, R.L.; McLaren, D.L.; Fu, H.; Harding, M.W.; Turnbull, G.D. Genetic Diversity and Aggressiveness of Fusarium Species Isolated from Soybean in Alberta, Canada. Crop Prot. 2018, 105, 49–58. [Google Scholar] [CrossRef]
- Chang, K.F.; Hwang, S.F.; Conner, R.L.; Ahmed, H.U.; Zhou, Q.; Turnbull, G.D.; Strelkov, S.E.; McLaren, D.L.; Gossen, B.D. First Report of Fusarium proliferatum Causing Root Rot in Soybean (Glycine max L.) in Canada. Crop Prot. 2015, 67, 52–58. [Google Scholar] [CrossRef]
- Abdelmagid, A.; Hafez, M.; Soliman, A.; Adam, L.R.; Daayf, F. First Report of Fusarium sporotrichioides Causing Root Rot of Soybean in Canada and Detection of the Pathogen in Host Tissues by PCR. Can. J. Plant Pathol. 2021, 43, 527–536. [Google Scholar] [CrossRef]
- Yang, X.B.; Feng, F. Ranges and Diversity of Soybean Fungal Diseases in North America. Phytopathology 2001, 91, 769–775. [Google Scholar] [CrossRef][Green Version]
- Pioli, R.N.; Mozzoni, L.; Morandi, E.N. First Report of Pathogenic Association Between Fusarium graminearum and Soybean. Plant Dis. 2004, 88, 220. [Google Scholar] [CrossRef]
- Zhao, L.; Wei, X.; Zheng, T.; Gou, Y.-N.; Wang, J.; Deng, J.-X.; Li, M. Evaluation of Pathogenic Fusarium Spp. Associated with Soybean Seed (Glycine max L.) in Hubei Province, China. Plant Dis. 2022, 106, 3178–3186. [Google Scholar] [CrossRef]
- Abdelmagid, A.; Hafez, M.; Lawley, Y.; Adam, L.R.; Daayf, F. First Report of Fusarium cerealis Causing Root Rot on Soybean. Plant Dis. 2018, 102, 2638. [Google Scholar] [CrossRef]
- Hartman, G.L. Compendium of Soybean Diseases and Pests, 5th ed.; APS Press, The American Phytopathological Society: St. Paul, MN, USA, 2015; ISBN 978-0-89054-473-0. [Google Scholar]
- Ellis, M.L.; Díaz Arias, M.M.; Leandro, L.F.; Munkvold, G.P. First Report of Fusarium armeniacum Causing Seed Rot and Root Rot on Soybean (Glycine max) in the United States. Plant Dis. 2012, 96, 1693. [Google Scholar] [CrossRef]
- Ellis, M.L.; Díaz Arias, M.M.; Cruz Jimenez, D.R.; Munkvold, G.P.; Leandro, L.F. First Report of Fusarium commune Causing Damping-off, Seed Rot, and Seedling Root Rot on Soybean (Glycine max) in the United States. Plant Dis. 2013, 97, 284. [Google Scholar] [CrossRef]
- Killebrew, J.F. Greenhouse and Field Evaluation of Fusarium solani Pathogenicity to Soybean Seedlings. Plant Dis. 1988, 72, 1067. [Google Scholar] [CrossRef]
- Cruz Jimenez, D.R.; Ellis, M.L.; Munkvold, G.P.; Leandro, L.F.S. Isolate–Cultivar Interactions, In Vitro Growth, and Fungicide Sensitivity of Fusarium oxysporum Isolates Causing Seedling Disease on Soybean. Plant Dis. 2018, 102, 1928–1937. [Google Scholar] [CrossRef]
- Chang, X.; Dai, H.; Wang, D.; Zhou, H.; He, W.; Fu, Y.; Ibrahim, F.; Zhou, Y.; Gong, G.; Shang, J.; et al. Identification of Fusarium Species Associated with Soybean Root Rot in Sichuan Province, China. Eur. J. Plant Pathol. 2018, 151, 563–577. [Google Scholar] [CrossRef]
- Zhang, J.X.; Xue, A.G.; Cober, E.R.; Morrison, M.J.; Zhang, H.J.; Zhang, S.Z.; Gregorich, E. Prevalence, Pathogenicity and Cultivar Resistance of Fusarium and Rhizoctonia Species Causing Soybean Root Rot. Can. J. Plant Sci. 2013, 93, 221–236. [Google Scholar] [CrossRef]
- Coleman, J.J. The Fusarium solani Species Complex: Ubiquitous Pathogens of Agricultural Importance. Mol. Plant Pathol. 2016, 17, 146–158. [Google Scholar] [CrossRef]
- Aoki, T.; O’Donnell, K.; Homma, Y.; Lattanzi, A.R. Sudden-Death Syndrome of Soybean Is Caused by Two Morphologically and Phylogenetically Distinct Species within the Fusarium solani Species Complex: F. virguliforme in North America and F. tucumaniae in South America. Mycologia 2003, 95, 660–684. [Google Scholar] [CrossRef]
- Šišić, A.; Baćanović-Šišić, J.; Al-Hatmi, A.M.S.; Karlovsky, P.; Ahmed, S.A.; Maier, W.; de Hoog, G.S.; Finckh, M.R. The ‘Forma Specialis’ Issue in Fusarium: A Case Study in Fusarium solani f. sp. pisi. Sci. Rep. 2018, 8, 1252. [Google Scholar] [CrossRef]
- O’Donnell, K. Molecular Phylogeny of the Nectria haematococca-Fusarium Solani Species Complex. Mycologia 2000, 92, 919–938. [Google Scholar] [CrossRef]
- Matuo, T. Use of Morphology and Mating Populations in the Identification of Formae Speciales in Fusarium solani. Phytopathology 1973, 63, 562. [Google Scholar] [CrossRef]
- Ellis, M.L.; Cruz Jimenez, D.R.; Leandro, L.F.; Munkvold, G.P. Genotypic and Phenotypic Characterization of Fungi in the Fusarium oxysporum Species Complex from Soybean Roots. Phytopathology 2014, 104, 1329–1339. [Google Scholar] [CrossRef]
- Torres-Cruz, T.J.; Whitaker, B.K.; Proctor, R.H.; Broders, K.; Laraba, I.; Kim, H.-S.; Brown, D.W.; O’Donnell, K.; Estrada-Rodríguez, T.L.; Lee, Y.-H.; et al. FUSARIUM-ID v.3.0: An Updated, Downloadable Resource for Fusarium Species Identification. Plant Dis. 2022, 106, 1610–1616. [Google Scholar] [CrossRef]
- Leslie, J.F.; Summerell, B.A. The Fusarium Laboratory Manual; John Wiley & Sons: Hoboken, NJ, USA, 2008; ISBN 978-0-470-27646-4. [Google Scholar]
- Toth, B.; Gyorgy, A.; Varga, M.; Mesterhazy, A. The Influence of the Dilution Rate on the Aggressiveness of Inocula and the Expression of Resistance against Fusarium Head Blight in Wheat. Plants 2020, 9, 943. [Google Scholar] [CrossRef]
- Takegami, S.; Sasai, K. Studies on Resistance of Wheat Varieties to Scab (Gibberella zeae (Schw.) Petch.): X. The Improved Method of Inoculation by Either Conidiospores or Hyphae of the Scab Cultured on Potato Agar Medium. Jpn. J. Crop Sci. 1970, 39, 1–6. [Google Scholar] [CrossRef][Green Version]
- Grausgruber, H.; Lemmens, M.; Buerstmayr, H.; Ruckenbauer, P. Evaluation of Inoculation Methods for Testing Fusarium Head Blight Resistance of Winter Wheat on Single Plant Basis. Bodenkult. Wien Munch. 1995, 46, 39–49. [Google Scholar]
- Stack, R.W. A Comparison of the Inoculum Potential of Ascospores and Conidia of Gibberella zeae. Can. J. Plant Pathol. 1989, 11, 137–142. [Google Scholar] [CrossRef]
- Vujanovic, V.; Hamel, C.; Yergeau, E.; St-Arnaud, M. Biodiversity and Biogeography of Fusarium Species from Northeastern North American Asparagus Fields Based on Microbiological and Molecular Approaches. Microb. Ecol. 2006, 51, 242–255. [Google Scholar] [CrossRef]
- Feng, J.; Hwang, R.; Chang, K.F.; Hwang, S.F.; Strelkov, S.E.; Gossen, B.D.; Conner, R.L.; Turnbull, G.D. Genetic Variation in Fusarium avenaceum Causing Root Rot on Field Pea. Plant Pathol. 2010, 59, 845–852. [Google Scholar] [CrossRef]
- van Diepeningen, A.D.; Brankovics, B.; Iltes, J.; van der Lee, T.A.J.; Waalwijk, C. Diagnosis of Fusarium Infections: Approaches to Identification by the Clinical Mycology Laboratory. Curr. Fungal Infect. Rep. 2015, 9, 135–143. [Google Scholar] [CrossRef]
- Porter, T.M.; Brian Golding, G. Are Similarity- or Phylogeny-Based Methods More Appropriate for Classifying Internal Transcribed Spacer (ITS) Metagenomic Amplicons? New Phytol. 2011, 192, 775–782. [Google Scholar] [CrossRef] [PubMed]
- White, T.; Bruns, T.; Lee, S.; Taylor, J.; Innis, M.; Gelfand, D.; Sninsky, J. Amplification and Direct Sequencing of Fungal Ribosomal RNA Genes for Phylogenetics. In PCR Protocols: A Guide to Methods and Applications; Academic Press: London, UK, 1990; Volume 31, pp. 315–322. [Google Scholar]
- Wang, M.; Chen, Q.; Diao, Y.; Duan, W.; Cai, L. Fusarium incarnatum-equiseti Complex from China. Persoonia 2019, 43, 70–89. [Google Scholar] [CrossRef]
- Kalman, B.; Abraham, D.; Graph, S.; Perl-Treves, R.; Meller Harel, Y.; Degani, O. Isolation and Identification of Fusarium spp., the Causal Agents of Onion (Allium cepa) Basal Rot in Northeastern Israel. Biology 2020, 9, 69. [Google Scholar] [CrossRef] [PubMed]
- Chen, Y.; Zhou, Q.; Strelkov, S.E.; Hwang, S.-F. Genetic Diversity and Aggressiveness of Fusarium spp. Isolated from Canola in Alberta, Canada. Plant Dis. 2014, 98, 727–738. [Google Scholar] [CrossRef]
- Kashyap, P.L.; Rai, S.; Kumar, S.; Srivastava, A.K.; Anandaraj, M.; Sharma, A.K. Mating Type Genes and Genetic Markers to Decipher Intraspecific Variability among Fusarium udum Isolates from Pigeonpea: Diversity Analysis of Fusarium udum Isolates. J. Basic Microbiol. 2015, 55, 846–856. [Google Scholar] [CrossRef]
- O’Donnell, K.; Rooney, A.P.; Proctor, R.H.; Brown, D.W.; McCormick, S.P.; Ward, T.J.; Frandsen, R.J.N.; Lysøe, E.; Rehner, S.A.; Aoki, T.; et al. Phylogenetic Analyses of RPB1 and RPB2 Support a Middle Cretaceous Origin for a Clade Comprising All Agriculturally and Medically Important Fusaria. Fungal Genet. Biol. 2013, 52, 20–31. [Google Scholar] [CrossRef]
- Dash, A.; Gurdaswani, V.; D’Souza, J.; Ghag, S. Functional Characterization of an Inducible Bidirectional Promoter from Fusarium oxysporum f. sp. cubense. Sci. Rep. 2020, 10, 2323. [Google Scholar] [CrossRef]
- Khuna, S.; Kumla, J.; Thitla, T.; Nuangmek, W.; Lumyong, S.; Suwannarach, N. Morphology, Molecular Identification, and Pathogenicity of Two Novel Fusarium Species Associated with Postharvest Fruit Rot of Cucurbits in Northern Thailand. J. Fungi 2022, 8, 1135. [Google Scholar] [CrossRef]
- Spanic, V.; Lemmens, M.; Drezner, G. Morphological and Molecular Identification of Fusarium Species Associated with Head Blight on Wheat in East Croatia. Eur. J. Plant Pathol. 2010, 128, 511–516. [Google Scholar] [CrossRef]
- Parikh, L.; Kodati, S.; Eskelson, M.J.; Adesemoye, A.O. Identification and Pathogenicity of Fusarium spp. in Row Crops in Nebraska. Crop Prot. 2018, 108, 120–127. [Google Scholar] [CrossRef]
- Moparthi, S.; Burrows, M.; Mgbechi-Ezeri, J.; Agindotan, B. Fusarium spp. Associated with Root Rot of Pulse Crops and Their Cross-Pathogenicity to Cereal Crops in Montana. Plant Dis. 2021, 105, 548–557. [Google Scholar] [CrossRef]
- Shabeer, S.; Tahira, R.; Jamal, A. Fusarium spp. Mycotoxin Production, Diseases and Their Management: An Overview. Pak. J. Agric. Res. 2021, 34, 278. [Google Scholar] [CrossRef]
- Safarieskandari, S.; Chatterton, S.; Hall, L.M. Pathogenicity and Host Range of Fusarium Species Associated with Pea Root Rot in Alberta, Canada. Can. J. Plant Pathol. 2021, 43, 162–171. [Google Scholar] [CrossRef]
- Ellis, M.L.; Munkvold, G.P. Trichothecene Genotype of Fusarium graminearum Isolates from Soybean (Glycine max) Seedling and Root Diseases in the United States. Plant Dis. 2014, 98, 1012. [Google Scholar] [CrossRef]
- Cruz, D.R.; Leandro, L.F.S.; Mayfield, D.A.; Meng, Y.; Munkvold, G.P. Effects of Soil Conditions on Root Rot of Soybean Caused by Fusarium graminearum. Phytopathology 2020, 110, 1693–1703. [Google Scholar] [CrossRef] [PubMed]
- Gaspar, A.P.; Marburger, D.A.; Mourtzinis, S.; Conley, S.P. Soybean Seed Yield Response to Multiple Seed Treatment Components across Diverse Environments. Agron. J. 2014, 106, 1955–1962. [Google Scholar] [CrossRef]
- Esker, P.D.; Conley, S.P. Probability of Yield Response and Breaking Even for Soybean Seed Treatments. Crop Sci. 2012, 52, 351–359. [Google Scholar] [CrossRef]
- McKenzie-Gopsill, A.; Beaton, A.; Foster, A.J. Investigating the Effects of Seed Treatments on the Economically Optimal Seeding Rate of Conventional Soybean in Atlantic Canada. Can. J. Plant Sci. 2022, 103, 201–213. [Google Scholar] [CrossRef]
- Nyandoro, R.; Chang, K.F.; Hwang, S.F.; Ahmed, H.U.; Turnbull, G.D.; Strelkov, S.E. Management of Root Rot of Soybean in Alberta with Fungicide Seed Treatments and Genetic Resistance. Can. J. Plant Sci. 2019, 99, 499–509. [Google Scholar] [CrossRef]
- Zhang, J.X.; Xue, A.G.; Tambong, J.T. Evaluation of Seed and Soil Treatments with Novel Bacillus Subtilis Strains for Control of Soybean Root Rot Caused by Fusarium oxysporum and F. graminearum. Plant Dis. 2009, 93, 1317–1323. [Google Scholar] [CrossRef]
- Wang, J.; Jacobs, J.L.; Roth, M.G.; Chilvers, M.I. Temporal Dynamics of Fusarium virguliforme Colonization of Soybean Roots. Plant Dis. 2019, 103, 19–27. [Google Scholar] [CrossRef]
- Herman, T.K.; Bowen, R.; Mahan, A.L.; Hartman, G.L. Evaluation of Soybean Germplasm for Resistance to Fusarium virguliforme, the Major Pathogen Causing Sudden Death Syndrome of Soybean in the United States. Crop Sci. 2023, 63, 1344–1353. [Google Scholar] [CrossRef]
- Kazi, S.; Shultz, J.; Afzal, J.; Johnson, J.; Njiti, V.N.; Lightfoot, D.A. Separate Loci Underlie Resistance to Root Infection and Leaf Scorch during Soybean Sudden Death Syndrome. Theor. Appl. Genet. 2008, 116, 967–977. [Google Scholar] [CrossRef][Green Version]
- Acharya, B.; Lee, S.; Rouf Mian, M.A.; Jun, T.-H.; McHale, L.K.; Michel, A.P.; Dorrance, A.E. Identification and Mapping of Quantitative Trait Loci (QTL) Conferring Resistance to Fusarium graminearum from Soybean PI 567301B. Theor. Appl. Genet. 2015, 128, 827–838. [Google Scholar] [CrossRef]
- Swaminathan, S.; Abeysekara, N.S.; Liu, M.; Cianzio, S.R.; Bhattacharyya, M.K. Quantitative Trait Loci Underlying Host Responses of Soybean to Fusarium virguliforme Toxins That Cause Foliar Sudden Death Syndrome. Theor. Appl. Genet. 2016, 129, 495–506. [Google Scholar] [CrossRef]
- Almeida-Silva, F.; Venancio, T.M. Integration of Genome-Wide Association Studies and Gene Coexpression Networks Unveils Promising Soybean Resistance Genes against Five Common Fungal Pathogens. Sci. Rep. 2021, 11, 24453. [Google Scholar] [CrossRef] [PubMed]
- Weinig, C.; Schmitt, J. Environmental Effects on the Expression of Quantitative Trait Loci and Implications for Phenotypic Evolution. BioScience 2004, 54, 627–635. [Google Scholar] [CrossRef][Green Version]
- Li, S.; Wang, J.; Zhang, L. Inclusive Composite Interval Mapping of QTL by Environment Interactions in Biparental Populations. PLoS ONE 2015, 10, e0132414. [Google Scholar] [CrossRef] [PubMed]
- Luckew, A.S.; Cianzio, S.R.; Leandro, L.F. Screening Method for Distinguishing Soybean Resistance to Fusarium virguliforme in Resistant × Resistant Crosses. Crop Sci. 2012, 52, 2215–2223. [Google Scholar] [CrossRef]
- Li, W.; Deng, Y.; Ning, Y.; He, Z.; Wang, G.-L. Exploiting Broad-Spectrum Disease Resistance in Crops: From Molecular Dissection to Breeding. Annu. Rev. Plant Biol. 2020, 71, 575–603. [Google Scholar] [CrossRef] [PubMed]
- Zhang, J.X.; Xue, A.G.; Zhang, H.J.; Nagasawa, A.E.; Tambong, J.T. Response of Soybean Cultivars to Root Rot Caused by Fusarium Species. Can. J. Plant Sci. 2010, 90, 767–776. [Google Scholar] [CrossRef]
- Kim, Y.M.; McLaren, D.; Conner, R.; Henriquez, M.A.; Abdelmagid, A.; Wu, L.; Hwang, S.-F.; Strelkov, S.; Chatterton, S.; Wally, O. The Fusarium Root Rot Complex of Soybean, Dry Bean and Field Pea in Manitoba, Canada. In Proceedings of the 12th International Congress of Plant Pathology, Lyon, France, 20–25 August 2023; pp. 1124–1125. [Google Scholar]
- Esmaeili Taheri, A.; Hamel, C.; Gan, Y.; Vujanovic, V. First Report of Fusarium redolens from Saskatchewan and Its Comparative Pathogenicity. Can. J. Plant Pathol. 2011, 33, 559–564. [Google Scholar] [CrossRef]
- O’Donnell, K.; Cigelnik, E. Two Divergent Intragenomic rDNA ITS2 Types within a Monophyletic Lineage of the Fungus Fusarium Are Nonorthologous. Mol. Phylogenetics Evol. 1997, 7, 103–116. [Google Scholar] [CrossRef] [PubMed]
- O’Donnell, K.; Kistler, H.C.; Cigelnik, E.; Ploetz, R.C. Multiple Evolutionary Origins of the Fungus Causing Panama Disease of Banana: Concordant Evidence from Nuclear and Mitochondrial Gene Genealogies. Proc. Natl. Acad. Sci. USA 1998, 95, 2044–2049. [Google Scholar] [CrossRef] [PubMed]
- Hall, T. BioEdit: A User-Friendly Biological Sequence Alignment Editor and Analysis Program for Windows 95/98/NT. Nucleic Acids Symp. Ser. 1999, 41, 95–98. [Google Scholar] [CrossRef]
- R Core Team. R: A Language and Environment for Statistical Computing; R Foundation for Statistical Computing: Vienna, Austria, 2022. [Google Scholar]
- Hoh, D.Z.; Lee, H.-H.; Wada, N.; Liu, W.-A.; Lu, M.R.; Lai, C.-K.; Ke, H.-M.; Sun, P.-F.; Tang, S.-L.; Chung, W.-H.; et al. Comparative Genomic and Transcriptomic Analyses of Trans-Kingdom Pathogen Fusarium solani Species Complex Reveal Degrees of Compartmentalization. BMC Biol. 2022, 20, 236. [Google Scholar] [CrossRef]
- Kolander, T.M.; Bienapfl, J.C.; Kurle, J.E.; Malvick, D.K. Symptomatic and Asymptomatic Host Range of Fusarium virguliforme, the Causal Agent of Soybean Sudden Death Syndrome. Plant Dis. 2012, 96, 1148–1153. [Google Scholar] [CrossRef] [PubMed]
- Chittem, K.; Khan, M.F.R.; Goswami, R.S. Efficacy of Precipitated Calcium Carbonate in Managing Fusarium Root Rot of Field Pea. Phytoparasitica 2016, 44, 295–303. [Google Scholar] [CrossRef]
- Goswami, R.S.; Kistler, H.C. Heading for Disaster: Fusarium graminearum on Cereal Crops. Mol. Plant Pathol. 2004, 5, 515–525. [Google Scholar] [CrossRef] [PubMed]
- Mueller, B.; Groves, C.L.; Smith, D.L. Chemotype and Aggressiveness Evaluation of Fusarium graminearum and Fusarium culmorum Isolates from Wheat Fields in Wisconsin. Plant Dis. 2021, 105, 3686–3693. [Google Scholar] [CrossRef] [PubMed]
- Laraba, I.; Ward, T.J.; Cuperlovic-Culf, M.; Azimi, H.; Xi, P.; McCormick, S.P.; Hay, W.T.; Hao, G.; Vaughan, M.M. Insights into the Aggressiveness of the Emerging North American Population 3 (NA3) of Fusarium graminearum. Plant Dis. 2023, 107, 2687–2700. [Google Scholar] [CrossRef] [PubMed]
- Wang, W.; Chen, L.; Fengler, K.; Bolar, J.; Llaca, V.; Wang, X.; Clark, C.B.; Fleury, T.J.; Myrvold, J.; Oneal, D.; et al. A Giant NLR Gene Confers Broad-Spectrum Resistance to Phytophthora sojae in Soybean. Nat. Commun. 2021, 12, 6263. [Google Scholar] [CrossRef] [PubMed]
- Sahoo, D.K.; Das, A.; Huang, X.; Cianzio, S.; Bhattacharyya, M.K. Tightly Linked Rps12 and Rps13 Genes Provide Broad-Spectrum Phytophthora Resistance in Soybean. Sci. Rep. 2021, 11, 16907. [Google Scholar] [CrossRef] [PubMed]
- Zhong, C.; Li, Y.; Sun, S.; Duan, C.; Zhu, Z. Genetic Mapping and Molecular Characterization of a Broad-Spectrum Phytophthora sojae Resistance Gene in Chinese Soybean. Int. J. Mol. Sci. 2019, 20, 1809. [Google Scholar] [CrossRef]
- Wang, D.; Chen, S.; Huang, Z.; Lin, J. Identification and Mapping of Genetic Locus Conferring Resistance to Multiple Plant Viruses in Soybean. Theor. Appl. Genet. 2022, 135, 3293–3305. [Google Scholar] [CrossRef]
- Yan, T.; Zhou, Z.; Wang, R.; Bao, D.; Li, S.; Li, A.; Yu, R.; Wuriyanghan, H. A Cluster of Atypical Resistance Genes in Soybean Confers Broad-Spectrum Antiviral Activity. Plant Physiol. 2021, 188, 1277–1293. [Google Scholar] [CrossRef]
- Pfordt, A.; Ramos Romero, L.; Schiwek, S.; Karlovsky, P.; von Tiedemann, A. Impact of Environmental Conditions and Agronomic Practices on the Prevalence of Fusarium Species Associated with Ear- and Stalk Rot in Maize. Pathogens 2020, 9, 236. [Google Scholar] [CrossRef] [PubMed]
- Pramunadipta, S.; Widiastuti, A.; Wibowo, A.; Suga, H.; Priyatmojo, A. Identification and Pathogenicity of Fusarium spp. Associated with the Sheath Rot Disease of Rice (Oryza sativa) in Indonesia. J. Plant Pathol. 2022, 104, 251–267. [Google Scholar] [CrossRef]
- Achari, S.R.; Kaur, J.; Dinh, Q.; Mann, R.; Sawbridge, T.; Summerell, B.A.; Edwards, J. Phylogenetic Relationship between Australian Fusarium oxysporum Isolates and Resolving the Species Complex Using the Multispecies Coalescent Model. BMC Genom. 2020, 21, 248. [Google Scholar] [CrossRef]
- Escamilla, D.; Rosso, M.L.; Zhang, B. Identification of Fungi Associated with Soybeans and Effective Seed Disinfection Treatments. Food Sci. Nutr. 2019, 7, 3194–3205. [Google Scholar] [CrossRef] [PubMed]
- Okello, P.N.; Petrović, K.; Kontz, B.; Mathew, F.M. Eight Species of Fusarium Cause Root Rot of Corn (Zea mays) in South Dakota. Plant Health Prog. 2019, 20, 38–43. [Google Scholar] [CrossRef]
- Singha, I.M.; Kakoty, Y.; Unni, B.G.; Das, J.; Kalita, M.C. Identification and Characterization of Fusarium spp. Using ITS and RAPD Causing Fusarium Wilt of Tomato Isolated from Assam, North East India. J. Genet. Eng. Biotechnol. 2016, 14, 99–105. [Google Scholar] [CrossRef]
- O’Donnell, K.; Sutton, D.A.; Rinaldi, M.G.; Gueidan, C.; Crous, P.W.; Geiser, D.M. Novel Multilocus Sequence Typing Scheme Reveals High Genetic Diversity of Human Pathogenic Members of the Fusarium incarnatum-F. equiseti and F. chlamydosporum Species Complexes within the United States. J. Clin. Microbiol. 2009, 47, 3851–3861. [Google Scholar] [CrossRef] [PubMed]
- James, J.E.; Santhanam, J.; Zakaria, L.; Mamat Rusli, N.; Abu Bakar, M.; Suetrong, S.; Sakayaroj, J.; Abdul Razak, M.F.; Lamping, E.; Cannon, R.D. Morphology, Phenotype, and Molecular Identification of Clinical and Environmental Fusarium solani Species Complex Isolates from Malaysia. J. Fungi 2022, 8, 845. [Google Scholar] [CrossRef] [PubMed]
- Nosratabadi, M.; Kachuei, R.; Rezaie, S.; Harchegani, A.B. Beta-Tubulin Gene in the Differentiation of Fusarium Species by PCR-RFLP Analysis. Infez. Med. 2018, 26, 52–60. [Google Scholar]
- O’Donnell, K.; Gräfenhan, T.; Laraba, I.; Busman, M.; Proctor, R.H.; Kim, H.-S.; Wiederhold, N.P.; Geiser, D.M.; Seifert, K.A. Fusarium abutilonis and F. guadeloupense, Two Novel Species in the Fusarium buharicum Clade Supported by Multilocus Molecular Phylogenetic Analyses. Mycologia 2022, 114, 682–696. [Google Scholar] [CrossRef]
- O’Donnell, K.; Whitaker, B.K.; Laraba, I.; Proctor, R.H.; Brown, D.W.; Broders, K.; Kim, H.-S.; McCormick, S.P.; Busman, M.; Aoki, T.; et al. DNA Sequence-Based Identification of Fusarium: A Work in Progress. Plant Dis. 2022, 106, 1597–1609. [Google Scholar] [CrossRef] [PubMed]
- Tian, Y.H.; Hou, Y.Y.; Peng, C.Y.; Wang, Y.Y.; He, B.L.; Gao, K.X. Genetic diversity and phylogenetic analysis of Fusarium oxysporum strains isolated from the Cucurbitaceae hosts revealed by SRAPs. Ying Yong Sheng Tai Xue Bao 2017, 28, 947–956. [Google Scholar] [CrossRef] [PubMed]

| Source of Variance | Df | Mean Square | |||||||
|---|---|---|---|---|---|---|---|---|---|
| Count1 | Count2 | Count3 | CountAve | Height | RRS | Shoot | Root | ||
| F.spp 1 | 12 | 10.4 *,2 | 4.1 * | 4.7 * | 5.5 * | 53.9 * | 11 * | 4.3 * | 0.2 * |
| CV 1 | 1 | 128.8 * | 70.1 * | 57.3 * | 82.7 * | 696.9 * | 10.7 * | 175.9 * | 9.5 * |
| Repeat 1 | 1 | 0.2 | 1.4 | 0.3 | 0.2 | 1.4 | 0.0 | 0.1 | 0.1 |
| F.spp:CV | 12 | 3.8 * | 2.6 * | 2.0 * | 2.6 * | 11.7 * | 1.0 * | 0.9 * | 0.1 * |
| F.spp:Repeat | 12 | 1.5 | 0.8 | 1.0 | 0.9 | 2.8 | 0.2 | 0.3 | 0.0 |
| CV:Repeat | 1 | 1.7 | 0.9 | 0.4 | 0.9 | 4.5 | 0.0 | 0.5 | 0.1 |
| F.spp:CV:Repeat | 12 | 0.8 | 0.9 | 1.0 | 0.8 | 3.5 | 0.2 | 0.2 | 0.0 |
| Residuals | 208 | 1.0 | 0.6 | 0.6 | 0.4 | 4.7 | 0.1 | 0.2 | 0.0 |
| Source of Variance | Df | Mean Square | ||||||
|---|---|---|---|---|---|---|---|---|
| Count1 | Count2 | Count3 | Height | RRS | Shoot | Root | ||
| F.spp 1 | 6 | 643.2 *,2 | 657.1 * | 709 * | 2946.8 * | 227.1 * | 28.9 * | 2.12 * |
| CV 1 | 19 | 28.0 * | 26.8 * | 25.8 * | 56.8 * | 2.0 * | 2.2 * | 0.18 * |
| Repeat 1 | 1 | 0.1 | 0.1 | 0.0 | 0.6 | 0.3 | 0.0 | 0.00 |
| CV:F.spp | 114 | 3.1 * | 2.8 * | 3.1 * | 15.8 * | 0.5 * | 0.2 * | 0.02 * |
| CV:Repeat | 19 | 0.6 | 0.6 | 0.6 | 1.3 | 0.2 | 0.0 | 0.00 |
| F.spp:Repeat | 6 | 1.0 | 1.7 | 1.3 | 0.6 | 0.5 | 0.0 | 0.00 |
| CV:F.spp:Repeat | 114 | 0.8 | 0.7 | 0.7 | 0.9 | 0.2 | 0.0 | 0.00 |
| Residuals | 839 | 1.6 | 1.6 | 1.5 | 2.4 | 0.3 | 0.1 | 0.01 |
Disclaimer/Publisher’s Note: The statements, opinions and data contained in all publications are solely those of the individual author(s) and contributor(s) and not of MDPI and/or the editor(s). MDPI and/or the editor(s) disclaim responsibility for any injury to people or property resulting from any ideas, methods, instructions or products referred to in the content. |
© 2024 by the authors. Licensee MDPI, Basel, Switzerland. This article is an open access article distributed under the terms and conditions of the Creative Commons Attribution (CC BY) license (https://creativecommons.org/licenses/by/4.0/).
Share and Cite
Wu, L.; Hwang, S.-F.; Strelkov, S.E.; Fredua-Agyeman, R.; Oh, S.-H.; Bélanger, R.R.; Wally, O.; Kim, Y.-M. Pathogenicity, Host Resistance, and Genetic Diversity of Fusarium Species under Controlled Conditions from Soybean in Canada. J. Fungi 2024, 10, 303. https://doi.org/10.3390/jof10050303
Wu L, Hwang S-F, Strelkov SE, Fredua-Agyeman R, Oh S-H, Bélanger RR, Wally O, Kim Y-M. Pathogenicity, Host Resistance, and Genetic Diversity of Fusarium Species under Controlled Conditions from Soybean in Canada. Journal of Fungi. 2024; 10(5):303. https://doi.org/10.3390/jof10050303
Chicago/Turabian StyleWu, Longfei, Sheau-Fang Hwang, Stephen E. Strelkov, Rudolph Fredua-Agyeman, Sang-Heon Oh, Richard R. Bélanger, Owen Wally, and Yong-Min Kim. 2024. "Pathogenicity, Host Resistance, and Genetic Diversity of Fusarium Species under Controlled Conditions from Soybean in Canada" Journal of Fungi 10, no. 5: 303. https://doi.org/10.3390/jof10050303
APA StyleWu, L., Hwang, S.-F., Strelkov, S. E., Fredua-Agyeman, R., Oh, S.-H., Bélanger, R. R., Wally, O., & Kim, Y.-M. (2024). Pathogenicity, Host Resistance, and Genetic Diversity of Fusarium Species under Controlled Conditions from Soybean in Canada. Journal of Fungi, 10(5), 303. https://doi.org/10.3390/jof10050303

